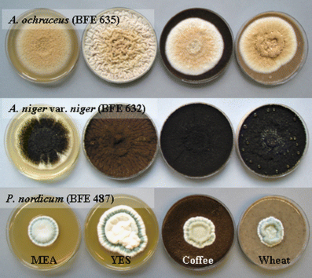

Abstract
Ochratoxin A (OTA) is one of the most widespread mycotoxins, and is produced by several Aspergillus or Penicillium species. Human exposure to OTA is mainly by intake of contaminated food, with cereal products, followed by coffee and red wine as the main sources of OTA. In this study, the OTA production of four ochratoxigenic fungi (two Aspergillus and two Penicillium species) was investigated in four different media, i.e. wheat and coffee model media as food-based media and two standard laboratory media (malt extract glucose agar, MEA and yeast extract sucrose agar, YES). Colony growth was documented and OTA concentrations in cultures were determined at day 2, 4 and 8 of incubation at 25°C by high-performance thin-layer chromatography (HPTLC) and high-performance liquid chromatography (HPLC). OTA production clearly depended upon time of incubation, fungal species, and medium composition. On coffee based medium, moderate OTA levels were produced by A. ochraceus BFE635 (9.8 μg/g) and by A. niger BFE632 (10.6 μg/g) on day 8 of incubation. In wheat-based medium, these strains produced much more OTA than in coffee. The highest OTA concentration (83.8 μg/g on day 8) was formed by A. ochraceus BFE635 followed by the other Aspergillus niger BFE632 (49 μg/g). Lower OTA levels were produced by P. verrucosum BFE550 and P. nordicum BFE487, in both wheat and in YES medium, whilst OTA was hardly detectable in coffee and in MEA in case of P. nordicum. Colony growth of the tested strains on different media was not indicative of OTA production. Guttation droplets developed on wheat-based medium with the Aspergillus strains within a week, and this phenomenon coincided with the high OTA amounts formed by these species. Results from this study add to our knowledge on the behaviour of ochratoxigenic fungal species when cultured on food based media.

Similar content being viewed by others
References
Abellana M, Sanches V, Ramos AJ (2001) Effect of water activity and temperature on growth of three Penicillium species and Aspergillus flavus on a sponge cake analogue. Int J Food Microbiol 71:151–157
Accensi F, Abarca ML, Cabañes FJ (2004) Occurrence of Aspergillus species in mixed feeds and component raw materials and their ability to produce ochratoxin A. Food Microbiol 21:623–627
Astoreca A, Magnoli C, Barbeis C, Chiacchiera SM, Combina M, Dalcero A (2007) Ochratoxin A production in relation to ecophysiological factors by Aspergillus section Nigri strains isolated from different substrates in Argentina. Sci Total Environ 388:16–23
Battilani P, Giorni P, Pietri A (2003) Epidemiology of toxin-producing fungi and ochratoxin A occurrence in grapes. Eur J Plant Pathol 109:715–722
Bejaoui H, Mathieu F, Taillandier P, Lebrihi A (2006) Biodegradation of ochratoxin A by Aspergillus section Nigri species isolated from French grapes: a potential means of ochratoxin A decontamination in grape juices and musts. FEMS Microbiol Lett 255:203–208
Betina V (1989) Chromatographic methods as tools in the field of mycotoxins. J Chromatogr 477:189–233
Bragulat MR, Abarca ML, Cabanes FJ (2001) An easy screening method for fungi producing ochratoxin A in pure culture. Int J Food Microbiol 71:139–144
Cabañes FJ, Bragula MR, Castellá G (2010) Ochratoxin A species in the genus Penicillium. Toxins 2:1111–1120
Calvo AM, Wilson RA, Bok JW, Keller NP (2002) Relationship between secondary meabolism and fungal development. Microbiol Mol Biol Rev 66:447–459
Czerwiecki L (2001) Ochratoxin A and other mycotoxins in Polish cereals and foods. Mycotoxin Res 17(2):125–128
Dall’Asta C, Galaverna G, De Dea LJ, Virgill R, Nevlani E, Dossena A (2007) A new validated HPLC-FL method for detecting ochratoxin A in dry-cured meat and blue cheese. Mycotoxin Res 23(3):132–137
Degen GH, Mayer S, Blaszkewicz M (2007) Biomonitoring of ochratoxin A in grain workers. Mycotoxin Res 23(2):88–93
Duarte SC, Pena A, Lino CM (2009) Ochratoxin A non-conventional exposure sources—a review. Microchem J 93:115–120
EC (2002) Assessment of dietary intake of ochratoxin A by the population of EU Member States. Report of the Scientific Cooperation, Task 3.2.7. Directorate-General Health and Consumer Protection, European Commission. Available at: http://europa.eu.int/comm/food/fs/scoop/3.2.7_en.pdf
EC (2006) Commission Regulation No 1881/2006 of 19 December 2006 setting maximum levels for certain contaminants in foodstuffs, L 364, 5–24
EFSA (2006) Opinion of the scientific panel on contaminants in the food chain on a request from the commission related to ochratoxin A in food. EFSA J 365:1–56
Esteban A, Abarca ML, Bragulat MR, Cabañes FJ (2004) Effects of temperature and incubation time on production of ochratoxin A by black Aspergilli. Res Micobiol 155:861–866
FAO (2001) Manual on the application of the HACCP system in mycotoxin prevention and control. FAO Food and Nutrition Paper 73
Frisvad J, Frank JM, Houbraken JA, Kuijpers AF, Samson RA (2004) New ochratoxin A producing species of Aspergillus section Circumdati. Stud Mycol 50:23–43
Frisvad JC, Thrane U, Samson RA, Pitt JI (2006) Important mycotoxins and the fungi which produce them. Adv Exp Med Biol 571:3–31
Gareis M, Gareis EM (2007) Guttation droplets of Penicillium nordicum and Penicillium verrucosum contain high concentrations of the mycotoxin ochratoxin A and B. Mycopathologia 163:207–214
Gareis M, Meussdoerffer F (2000) Dust of grains and malts as a source of ochratoxin A exposure. Mycotoxin Res 16A:127–130
Hocking AD, Leong SIL, Kazi BA, Emmett RW, Scott ES (2007) Fungi and mycotoxins in vineyards and grape products. Int J Food Microbiol 119:84–88
IARC (1993) Ochratoxin A. Some naturally occurring substances: food items and constituents, heterocyclic aromatic amines and mycotoxins. IARC monograph on the evaluation of carcinogenic risk to humans, vol 56, IARC Press, Lyon, pp. 489–521
JECFA (1996) Toxicological evaluation of certain food additives and contaminants in food: ochratoxin A. Forty-fourth meeting of the joint FAO/WHO expert committee on food additives. WHO Food Additives Series 35. IPCS WHO, Geneva, pp 363–376
Krogh P (1992) Role of ochratoxin in disease causation. Food Chem Toxicol 30(3):213–224
Kuiper-Goodman T, Hilts C, Billiard SM, Kiparissis Y, Richard IDK, Hayward S (2010) Health risk assessment of ochratoxin A for all age-sex strata in a market economy. Food Addit Contam 27(2):212–240
Larsen TO, Svendsen A, Smedsgaard J (2001) Biochemical characterization of ochratoxin A-producing strains of the genus Penicillium. Appl Environ Microbiol 67(8):3630–3635
Lucchetta G, Bazzo I, Dal Cortivo G, Stringher L, Bellotto D, Borgo M, Angelini E (2010) Occurrence of black Aspergilli and ochratoxin A on grapes in Italy. Toxins 2:840–855
Magan N, Aldred D (2005) Conditions of formation of ochratoxin A in drying, transport and in different commodities. Food Addit Contam 1:10–16
Magan N, Aldred D (2007) Post-harvest control strategies: minimizing mycotoxins in the food chain. Int J Food Microbiol 119:131–139
Mateo R, Medina A, Mateo EM, Matero F, Jiménez M (2007) An overview of ochratoxin A in beer and wine. Int J Food Microbiol 119:79–83
Morello LG, Sartori D, de Oliveira Martinez AL, Vieira MLC, Taniwaki MH, Pelegrinelli MH (2007) Detection and quantification of Aspergillus westerdijkiae in coffee beans based on selective amplification of β-tubulin gene by using real-time PCR. Int J Food Microbiol 119:270–276
Noonim P, Mahakarnchanakul W, Nielsen KF, Frisvad JC, Samson RA (2008) Isolation, identification and toxigenic potential of ochratoxin A-producing Aspergillus species from coffee beans grown in two regions of Thailand. Int J Food Microbiol 128:197–202
Nordic Working Group on Food Toxicology and Risk Evaluation (1991) Health evaluation of ochratoxin A in food products. Nordiske Seminar og Arbejdsrapporter 545. Nordic Council of Ministers, Copenhagen
Palacios-Cabrera H, Taniwaki MH, Menezes HC, Iamanaka BT (2001) The production of ochratoxin A by Aspergillus ochraceus in raw coffee at different equilibrium relative humidity and under alternating temperatures. Food Control 15:531–535
Pardo E, Sanchiz V, Ramos AJ, Marín S (2006) Non-specificity of nutritional substrate for ochratoxin A production by isolates of Aspergillus ochraceus. Food Microbiol 23:351–358
Petzinger E, Weidenbach A (2002) Mycotoxins in the food chain: the role of ochratoxins. Livest Prod Sci 76:245–250
Pfohl-Leszkowicz A, Petkova-Bocharova T, Chernozemsky IN, Castegnaro M (2002) Balkan endemic nephropathy and associated urinary tract tumours: a review on aetiological causes and the potential role of mycotoxins. Food Addit Contam 19(3):282–302
Ramos AJ, Labernia N, Marín S, Sanchis MN (1998) Effect of water activity and temperature on growth and ochratoxin production by three strains of Aspergillus ochraceus on a barley extract medium and on barley grains. Int J Food Microbiol 44:133–140
Richard JL, Plattner RD, May J, Liska SL (1999) The occurrence of ochratoxin A in dust collected from a problem household. Mycopathologia 146:99–103
Richter WIF, Baranowski A, Schuster M, Scholz W (2001) Bildung von Ochratoxin A bei der Lagerung von Triticale nach künstlicher Infektion mit Penicillium verrucosum in Abhängigkeit unterschiedlicher Feuchtegehalte. Mycotoxin Res 23(2):193–197
Saxena J, Munimbazi C, Bullerman LB (2001) Relationship of mould count, ergosterol and ochratoxin A production. Int J Food Microbiol 71:29–34
Schmidt-Heydt M, Bode H, Raupp F, Geisen R (2010) Influence of light on ochratoxin biosynthesis by Penicillium. Mycotoxin Res 26(1):1867–1632
Schmidt-Heydt M, Rüfer C, Raupp F, Bruchmann A, Perrone G, Geisen R (2011) Influence of light on food relevant fungi with emphasis on ochratoxin A producing species. Int J Food Microbiol 145(1):229-237
Scott PM (2002) Methods of analysis for ochratoxin A. Adv Exp Med Biol 504:117–134
Scott PM (2005) Biomarkers of human exposure to ochratoxin A. Food Addit Contam 1:99–107
Scott PM, Lawrence JW, van Walbeek W (1970) Detection of mycotoxins by thin-layer chromatography: application to screening of fungal extracts. Appl Microbiol 20:839–842
Skrinjar M, Dimic G (1992) Ochratoxigenicity of Aspergillus ochraceus group and Penicillium verrucosum var. cyclopium strains on various media. Acta Microbiol Hung 39:257–261
Studer-Rohr I, Dietrich DR, Schlatter J, Schlatter C (1995) The occurrence of ochratoxin A in coffee. Food Chem Toxicol 33(5):341–355
Suárez-Quiroz M, González-Rios O, Barel M, Guyot B, Schorr-Galindo S, Guiraud JP (2004a) Study of ochratoxin A-producing strains in coffee processing. Int J Food Sci Technol 39:1–7
Suárez-Quiroz M, González-Rios O, Barel M, Guyot B, Schorr-Galindo S, Guiraud JP (2004b) Effect of chemical and environmental factors on Aspergillus ochraceus growth and toxigenesis in green coffee. Food Microbiol 21:629–634
Taniwaki MH, Pitt JI, Teixeira AA, Iamanaka BT (2003) The source of ochratoxin A in Brazilian coffee and its formation in relation to processing methods. Int J Food Microbiol 82:173–179
Tèren J, Varga J, Hamari Z, Rinyu E, Kevei F (1996) Inmunochemical detection of ochratoxin A in black Aspergillus strains. Mycopathologia 134:171–176
Varga J, Kevel E, Rinyu E, Téren J, Kozakiewicz Z (1996) Ochratoxin production by Aspergillus species. Appl Environ Microbiol 62:4461–4464
Varga J, Péteri Z, Tábori K, Téren J, Vágvölgyi C (2005) Degradation of ochratoxin A and other mycotoxins by Rhizopus isolates. Int J Food Microbiol 99:321–328
Vega M, Muñoz K, Sepúlveda C, Aranda M, Campos V, Villegas R, Villaroel O (2009) Solid-phase extraction and HPLC determination of ochratoxin A in cereal products on Chilean market. Food Control 20:631–634
Zimmerli B, Dick R (1995) Determination of ochratoxin A at the ppt level in human blood, serum, milk and some foodstuffs by high-performance liquid chromatography with enhanced fluorescence detection and immunoaffinity column cleanup: methodology and Swiss data. J Chromatogr B Biomed Appl 666(1):85–99
Acknowledgements
The authors want to thank the Master in Pharmaceutical Science program of the University of Concepción, Chile. K.M. acknowledges valuable guidance of Dr. P. Färber and Dr. R. Madariaga.
Author information
Authors and Affiliations
Corresponding author
Electronic supplementary material
Fig 5
Colony morphology of Aspergillus ochraceus BFE 635 colonies after 2, 4 and 8 days of growth on standard media (MEA and YES) and food based media (coffee and wheat) at 25°C in darkness (JPEG 64 kb)
Fig 6
Colony morphology of Aspergillus niger var. niger BFE632 after 2, 4 and 8 days of growth on standard media (MEA and YES) and food based media (coffee and wheat) at 25°C in darkness (JPEG 64 kb)
Fig 7
Colony morphology of Penicillium verrucosum BFE550 after 2, 4 and 8 days of growth on standard media (MEA and YES) and food based media (coffee and wheat) at 25°C in darkness (JPEG 58 kb)
Fig 8
Colony morphology of Penicillium nordicum BFE 487 after 2, 4 and 8 days of culture on standard media (MEA and YES) and food based media (coffee and wheat) at 25°C in darkness (JPEG 57 kb)
Fig 9
HPTLC plates of culture extracts from the strains A. ochraceus BFE635 [A], A. niger BFE632 [B], P. nordicum BFE487 [C], and P. verrucosum BFE550 [D] as viewed under UV light at 366 nm. Extracts of cultures after growth for 2, 4 and 8 day on different media (MEA, YES, Coffee, Wheat) were analyzed as described in the Methods section (JPEG 53 kb)
Fig. 10
Representative chromatograms of extracts from Penicillium nordicum BFE487 cultures on standard (MEA and YES) and food based media (Coffee and Wheat). Samples were collected at day 2, 4 and 8 of culture and analyzed by HPLC with fluorescence detection as described in the Methods section (JPEG 55 kb)
Rights and permissions
About this article
Cite this article
Muñoz, K., Vega, M., Rios, G. et al. Mycotoxin production by different ochratoxigenic Aspergillus and Penicillium species on coffee- and wheat-based media. Mycotoxin Res 27, 239–247 (2011). https://doi.org/10.1007/s12550-011-0100-0
Received:
Revised:
Accepted:
Published:
Issue Date:
DOI: https://doi.org/10.1007/s12550-011-0100-0




